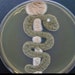

Rabbit Mill is a veteran owned farm in central Pennsylvania. We primarily raise Californian and New Zealand rabbits . We are quickly becoming a premier substrate producer in the area thanks to many very talented bunnies that love to poop.
All items

Reviews
-
Kundalini on Sep 21, 2023
5 out of 5 starsWas my first time buying sterilized rabbit substrate and i am loving it, it is a superior substrate and it has a beautiful smell I will be back for much more
-

Jeffrey on Aug 24, 2023
5 out of 5 starsExcellent bags! I’ll reuse them for compost teas for my organic living soil & gardens [=
-

Jeffrey on Aug 24, 2023
5 out of 5 starsAll arrived well, thanks! Will try to do a follow up review when I see how well the bunny poo does it’s job [=
-

Natalie on Aug 13, 2023
5 out of 5 starsVery good quality and this product has continued to meet my expectations!
-

Neal on Aug 13, 2023
5 out of 5 starsMy new favorite seller! This product is absolutely amazing, pics are 3 days into bulk colonization. The seller went above and beyond with communication and even names a bunny after a name I chose, which they sent info about after! Such a sweet seller and hope to buy more soon:)
-

Cecilia on Aug 4, 2023
5 out of 5 starsThis is the shop i will go back to in the future when I need more rabbit manure for my garden. Speedy shipping, careful and neat packing, the quality of manure.. I’m very happy with this experience. Highly recommended.
-

Tim on Jul 18, 2023
5 out of 5 starsThe owner goes all out to satisfy his customers speedy delivery and promptly answered all my questions i will definitely purchase from him again the canvas bag fits perfect
-

Natalie on Jul 15, 2023
5 out of 5 starsThis is a great quality bag, and also very friendly service!
-

Marionette on Jul 11, 2023
5 out of 5 starsThis Burlap Substrate bag w/drawstrings is exactly what I needed for my project. The size is perfect and it serves its purpose very well. The seller is responsive and helpful.
-

Paula on Jul 9, 2023
5 out of 5 starsI absolutely love this small burlap bag! The quality of the material is excellent, and perfect to use for what I need it for. Seller was quick with responses and shipping was speedy! I will definitely be buying other products from this seller in the future.
About RabbitMill
-
 Hard at work doing what I do best.
Hard at work doing what I do best.
Production partners
-
Animal Husbandry facility
Hebei, China
This is an Animal Husbandry development company in China. They focus on rabbits and help me to produce various design ideas to improve my rabbitry.
-
Rabbit Mill Bunnies
New Columbia, PA
Lots of rabbits pooping out mushroom food 24 hours a day. We make the poo. We mix it. We bag it. We cook it. Our human slaves do the rest.
Shop policies
Shipping
Payment options
Returns & exchanges
Cancellations
Cancellations: accepted
Request a cancellation: before item has shipped






